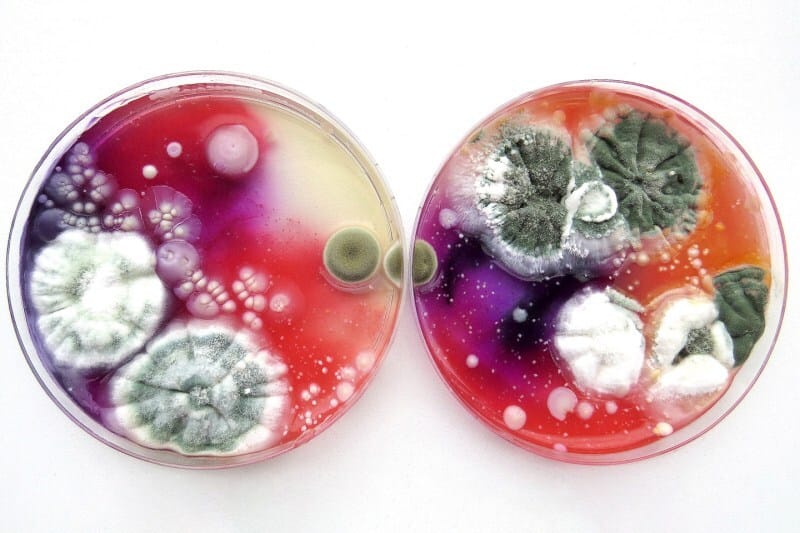
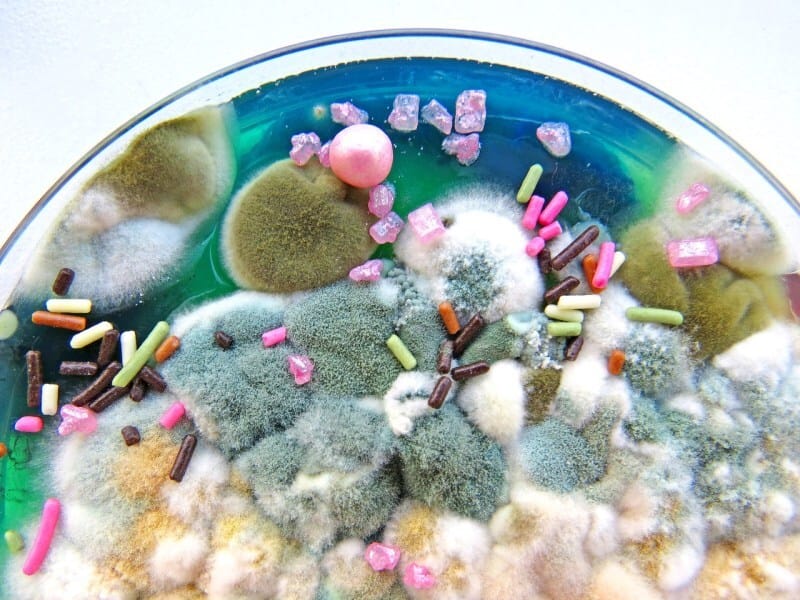
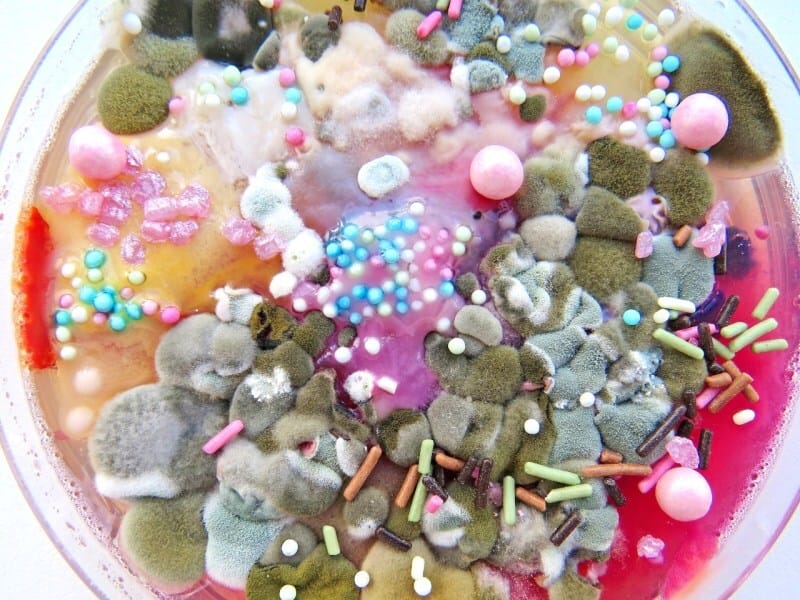
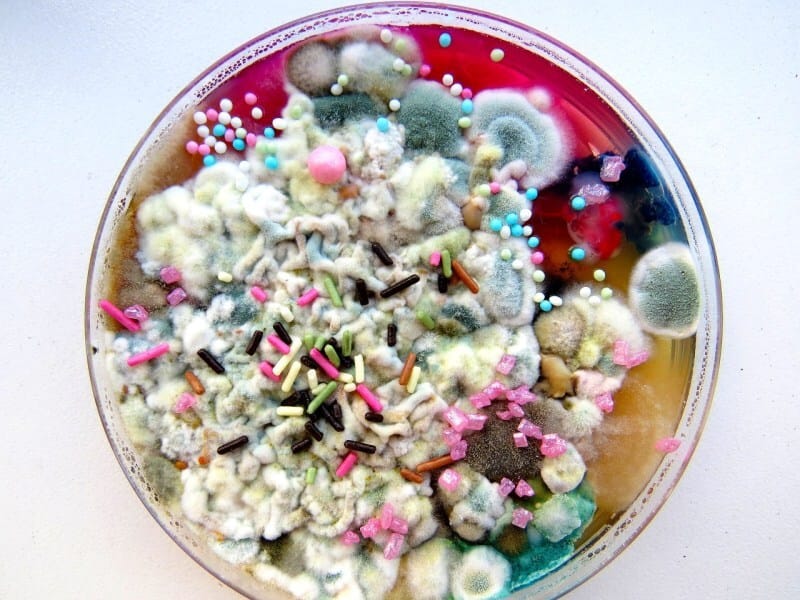
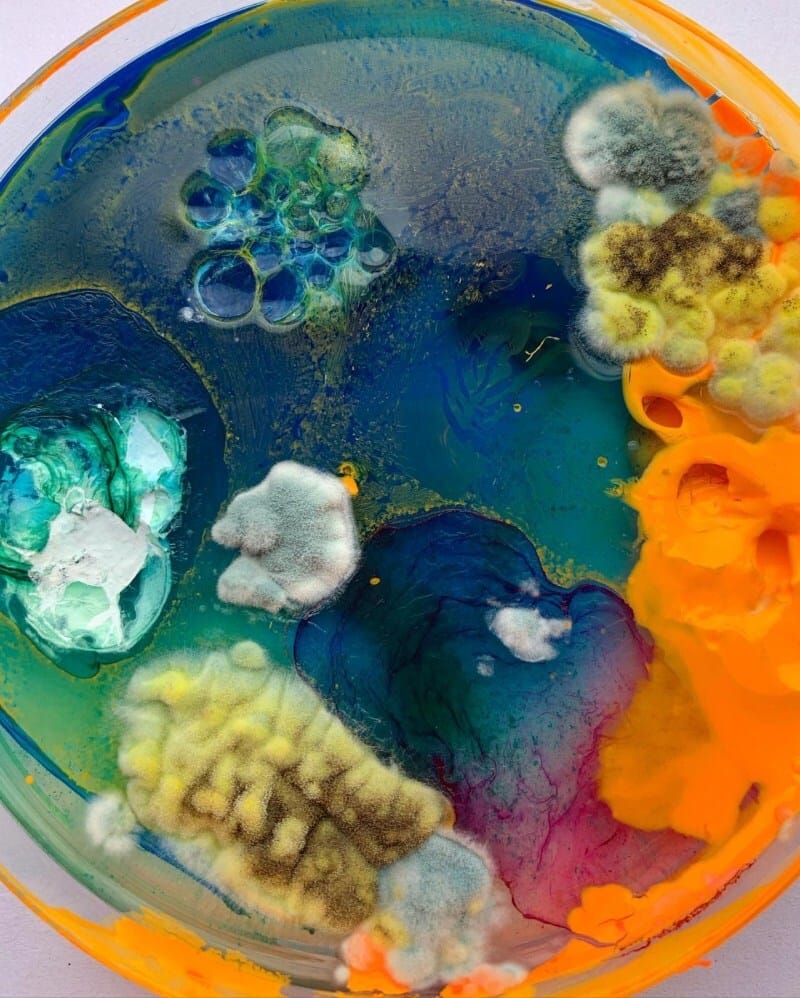

Who said decay can’t be beautiful?
These hyper-vibrant moldscapes are the work of Dasha Plesen, combining paint, food, cultures and bacteria to create Petri dish masterpieces.
Simultaneously beautiful and gross, the art pieces are grown over a period of 3-4 weeks, each one developing into something new and unexpected during that time period.
The multitude of different textures and makeups is impressive, if also a bit vomit-worthy at the same time.

Images © Copyright Dasha Plesen.
The post Marvelous Mold and Fabulous Fungus appeared first on Moss and Fog.
